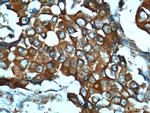
TIMP1 Antibody in Immunohistochemistry (Paraffin) (IHC (P))

Search
Proteintech
TIMP1 Polyclonal Antibody
{{$productOrderCtrl.translations['antibody.pdp.commerceCard.promotion.promotions']}}
{{$productOrderCtrl.translations['antibody.pdp.commerceCard.promotion.viewpromo']}}
{{$productOrderCtrl.translations['antibody.pdp.commerceCard.promotion.promocode']}}: {{promo.promoCode}} {{promo.promoTitle}} {{promo.promoDescription}}. {{$productOrderCtrl.translations['antibody.pdp.commerceCard.promotion.learnmore']}}
产品信息
16644-1-AP
种属反应
已发表种属
宿主/亚型
分类
类型
抗原
偶联物
形式
浓度
规格
纯化类型
保存液
内含物
保存条件
运输条件
产品详细信息
Immunogen sequence: MAPFEPLAS GILLLLWLIA PSRACTCVPP HPQTAFCNSD LVIRAKFVGT PEVNQTTLYQ RYEIKMTKMY KGFQALGDAA DIRFVYTPAM ESVCGYFHRS HNRSEEFLIA GKLQDGLLHI TTCSFVAPWN SLSLAQRRGF TKTYTVGCEE CTVFPCLSIP CKLQSGTHCL WTDQLLQGSE KGFQSRHLAC LPREPGLCTW QSLRSQIA (1-207 aa encoded by BC000866)
靶标信息
TIMP1 (metalloproteinase inhibitor 1) is a metalloproteinase inhibitor that functions by forms one-to-one complexes with target metallproteinases, such as collagenases, and irreversible inactivates them by binding to their catalytic zinc cofactor. TIMP1 acts on MMP1, MMP2, MMP3, MMP7, MMP8, MMP9, MMP10, MMP11, MMP12, MMP14, and MMP16. It also functions as a growth factor that regulates cell differenation, migration, and cell death. TIMP1 activates cellular signaling cascades via CD63 and ITGB1.
仅用于科研。不用于诊断过程。未经明确授权不得转售。
生物信息学
蛋白别名: Collagenase inhibitor; EPA; epididymis secretory sperm binding protein; erythroid potentiating activity; Erythroid-potentiating activity; Fibroblast collagenase inhibitor; FLJ90373; Metalloproteinase inhibitor; Metalloproteinase inhibitor 1; MMP inhibitor; prefibroblast collagenase inhibitor; RP1-230G1.3; TIMP; TIMP 1; TIMP-1; TIMP1; Tissue inhibitor of metalloproteinases 1; unnamed protein product
基因别名: CLGI; EPA; EPO; HCI; TIMP; TIMP-1; TIMP1
UniProt ID: (Human) P01033
Entrez Gene ID: (Human) 7076